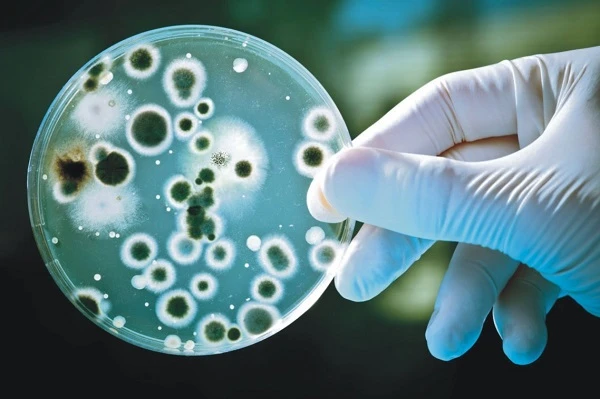

Наказ про створення медичної команди з вакцинації
Нинішня система проведення епідеміологічних розслідувань інфекційних захворювань в Україні не дає очікуваних результатів, вважають у МОЗ. Це впливає на рівень захворюваності інфекційними хворобами.
✅✅✅ Положення про преміювання працівників медичного закладу: як розробити
«Реальний рівень інфекційної захворюваності значно перевищує дані офіційної статистики Міністерства охорони здоров’я України. Заниження статистичних даних є суттєвою проблемою, а якість даних загалом є недостатньою, що погіршує спроможності країни у виявленні хвороб та вжитті заходів у разі епідемічних спалахів», — йдеться у пояснювальній записці до проєкту наказу.
Тому запропонований на громадське обговорення документ має визначити чіткий порядок проведення епідеміологічного обстеження (розслідування) епідемій та спалахів інфекційних хвороб на різних організаційних рівнях. Його автори:
- сформулювали перелік інфекційних хвороб та патогенів, що підлягають епідеміологічному нагляду
- визначили функції лабораторій системи громадського здоров’я для епідеміологічного нагляду
Запропонований порядок містить 10 розділів:
- Загальні положення
- Підготовка до розслідування
- Підтвердження наявності спалаху
- Підтвердження діагнозу
- Повідомлення комісії з розслідування спалахів інфекційних хвороб та робота комісії
- Систематичний пошук випадків та реєстрація даних
- Огляд та санітарне обстеження осередку
- Формулювання та оцінювання гіпотез
- Здійснення протиепідемічних та профілактичних заходів
- Продовження епідеміологічного нагляду та звітність про результати роботи
Якщо Порядок затвердять він поширюватиметься на заклади охорони здоров’я незалежно від форми власності та підпорядкованості, фізичних осіб — підприємців, які одержали ліцензію на провадження господарської діяльності з медичної практики, територіальні органи Держпродспоживслужби та Державну санітарно-епідеміологічну службу СБУ.
Нагадаємо, раніше КМУ схвалив концепцію надання меддопомоги пацієнтам із рідкісними захворюваннями до 2026 року.
За матеріалами сайту МОЗ

